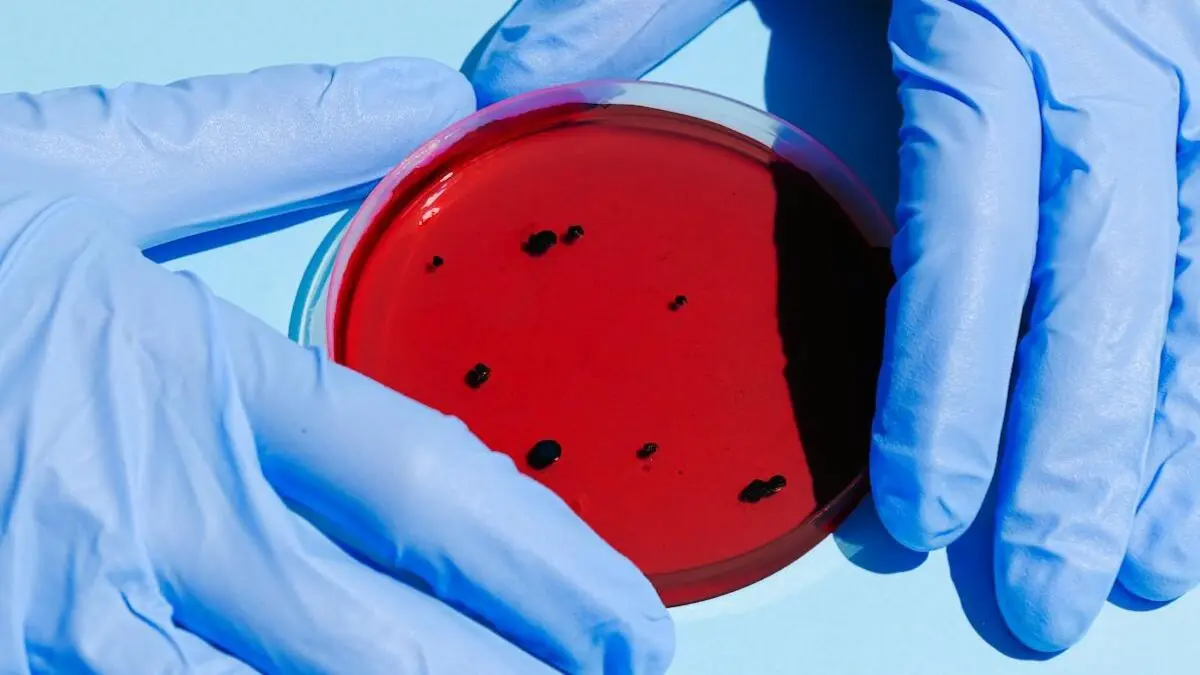
Norovirus.

All About Norovirus Outbreak In US: Know Symptoms, Steps To Protect Yourself
Recently, the CDC highlighted outbreaks of GI illness on cruise ships within the VSP jurisdiction, raising growing concerns among the public.
- Health News
- 2 min read
Norovirus outbreak in the US: In 1968, Norovirus was named after Norwalk, Ohio, in the United States, where the disease was first identified as the ‘Norwalk agent.’ The outbreak occurred when children at Bronson Elementary School exhibited symptoms of acute gastroenteritis.
Norovirus typically peaks between the months of November and April. Marking a significant spike, the U.S. Centers for Disease Control and Prevention (CDC) reported 91 outbreaks by the end of 2024, reflecting a notable increase compared to previous years.
Recently, the CDC again highlighted outbreaks of gastrointestinal (GI) illness on cruise ships within the Vessel Sanitation Program's (VSP) jurisdiction, raising growing concerns among the public.
Advertisement
Symptoms of Norovirus
Individuals suffering from GI illness may experience symptoms such as vomiting, along with one or more of the following: diarrhea, muscle aches, headaches, abdominal cramps, or fever, according to the CDC.
Steps to protect yourself from Norovirus
Protecting yourself from Norovirus primarily involves maintaining good hygiene. This includes washing your hands with soap or using hand sanitizer when soap is unavailable. Be sure to thoroughly wash fruits and vegetables before consumption.
Advertisement
Discard any foods that may have been exposed to the virus, as Noroviruses are relatively resistant to heat and can survive temperatures as high as 145°F. The CDC explains that “quick steaming processes will not heat foods enough to kill noroviruses.”
Additionally, remember to wear gloves when handling potentially contaminated items, disinfect surfaces frequently, and wash clothes and linens regularly when needed to reduce the risk of infection.